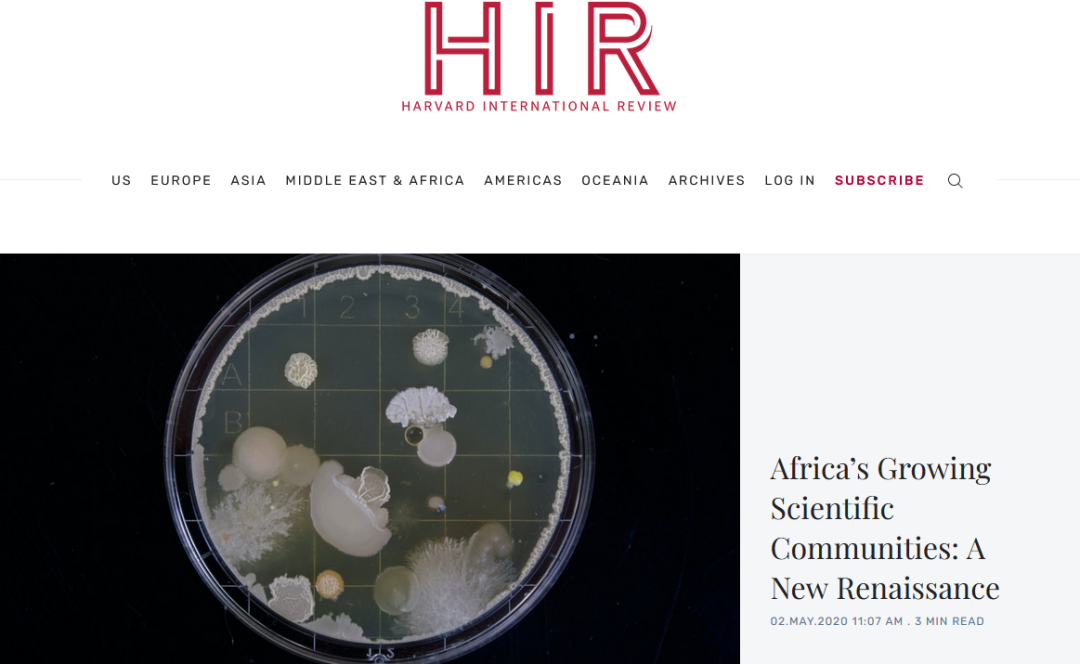

HIR哈佛国际评论写作竞赛介绍
《哈佛国际评论》中学生学术写作挑战赛,Harvard International Review ,简称HIR,是由《哈佛国际评论》举办,面向全球9-12年级中学生的学术写作竞赛。参赛学生以某个关乎人类未来共同命运的本土或国际问题为主题,写作一篇800-1200英文单词的学术文章。
《哈佛国际评论》创刊于1979年,是全球顶级社科学术期刊,每期发行量超过10万。主要刊载哈佛学子对于国际事务的多角度看法和理解。供稿人包括学者、教授、领导人、国际问题专家等全世界范围内知名人士。目前已有43位总统和总理、4位联合国秘书长、11位诺贝尔奖获得者发表过评论文章。其编委会由哈佛优秀学者组成,哈佛教授指导。
这一期刊是全球多所名校的必读读物之一。《哈佛国际评论》作为顶级学术期刊,每周都会发表各领域的国际问题研究论文。因此也备受全世界关注,其举办的写作竞赛也吸引了世界各地的目光!
由《哈佛国际评论》期刊编辑、哈佛学者组成的评委会,将评审来自全球各地的投稿作品,评选出各级奖项。
作品晋级决赛的参赛者,将受邀参加线上答辩会,体验学术答辩经历,获得评审团的反馈意见。每届赛事的部分优秀作品,将获得《哈佛国际评论》的表彰提名及发表。
领取HIR报名表
HIR竞赛含金量
为人类共同命运发声 参加哈佛答辩日
优秀作品获《哈佛国际评论》提名发表
HIR竞赛时间
有三个不同的提交周期,作品晋级决赛的参赛者,将受邀参加线上学术答辩会,获得评审团的反馈意见
春季赛
提交截止:2026年5月31日
决赛答辩:2026年6月29日
夏季赛
提交截止:2026年8月31日
决赛答辩:2026年10月5日
秋冬季赛
提交截止:2027年1月2日
决赛答辩:2027年2月5日
HIR竞赛奖项设置
所有提交的作品都将获得《哈佛国际评论》的字母等级,所有评级和奖项决定均为最终决定,除了哈佛评分员提供的成绩外,比赛将无法提供额外的细节
表彰奖
HIR证书
优秀写作内容/风格奖
HIR证书
高度表彰奖
HIR证书
铜奖(全球前20%)
HIR证书,姓名将在网站上公布
银奖(全球前10%)
HIR证书,姓名将在网站上公布
金奖(全球前3%)
HIR证书,姓名将在网站上公布
参赛者需要注册并付款然后才有资格在提交截止日期之前提交他们的文章
HIR竞赛投稿指南-要求
受到全球不断增长的高中读者群的启发,《哈佛国际评论》创建了哈佛国际评论学术写作大赛,以鼓励和突出与国际事务相关的优秀高中写作。

HAWC竞赛资格
初级组:适合7-8年级学生(2026年新增)
高级组:适合9-12年级学生
传统的高中组 - 面向全球9到12年级的高中生,要求撰写关于国际事务相关且具有深度的主题短文。
新增低年级组 - 面向全球7到8年级的初中生,主题有所不同。
HIR报名HIR写作主题
初级组竞赛主题:
✨ 主题:改变人类生活的发明创造
Theme:Inventions that Changed How We Live
高级组竞赛主题:
✨ 主题A:数字时代的全球文化
Theme A: Global Culture in the Digital Era
✨ 主题B:多极化世界中的安全格局
Theme B: Security in a Multipolar World
✨ 主题C:科技、创新与权力博弈
Theme C: Technology, Innovation, and Power
*学生可从上述三个主题中任选一个进行写作

参赛者在撰写文章时可以选择上述任一主题
内容:文章应涉及与当今国际事务相关的主题。潜在类别包括(但不限于):农业、商业、网络安全、国防、教育、就业和移民、能源与环境、金融与经济、公共卫生、科学与技术、太空、贸易和运输。文章应该从全球角度审视这个主题,而不是关注美国。
长度: 文章应至少 800 字但不超过 1,200 字(不包括图表、数据表或作者声明)。
写作风格: 提交的内容应就一个未被充分重视的全球话题提出有分析依据的观点。
AI政策:禁止使用ChatGPT。评委将通过多个 AI 检查器运行所有文章,在多个检查器中获得高 AI 生成分数的文章将被取消资格。
优秀的参赛作品将旨在从平衡的角度全面呈现一个主题。证据和细微差别至关重要。提交的作品应经过充分研究,消息灵通,风格和散文形式正式。
HIR 不接受专栏文章,也称为社论或评论文章。文章应该有论文,但不应该有议程。提交的材料也不应仅仅是事实的集合。
作为一个记者组织,我们要求提交的内容遵循 AP Style 的最新版本。我们还要求提交的内容具有文化敏感性、经过事实核查和尊重。
HIR投稿
HIR主题-热门话题领域
13个热门话题领域-可供参赛者自主选择
农业
Agriculture
商业
Business
网络安全
Cybersecurity
教育
Education
能源与环境
Energy&Environment
金融与经济
Finance&Economics
就业与移民
Employment&Immigration
贸易
Trade
交通
Transportation
太空
Space
国防
Defense
公共健康
Public Health
科学与技术
Science&Technology
HIR竞赛注册页面
欢迎使用中国区官方报名通道:每期投稿名额有限,额满关闭报名通道

HIR论文提交指南
请注意:所有低年级组参赛者必须遵守高中组比赛的投稿指南!
文章内容
文章应探讨与当今国际事务相关的议题。潜在类别包括(但不限于):农业、商业、网络安全、国防、教育、就业与移民、能源与环境、金融与经济、公共卫生、科学技术、太空、贸易和交通运输。
文章应从全球视角审视主题,而不是仅仅关注美国。
文章长度
文章长度应至少为800字,但不超过1200字(不包括图表、数据表格或作者声明)。
写作风格
文章应就一个被低估的全球性议题,提出有分析依据的观点。
人工智能使用政策
严禁使用 ChatGPT 和其他人工智能工具和软件!评委将使用多个AI检测工具对所有文章进行检测,在多个检测工具中获得高AI生成分数(即被判定为由AI生成)的文章将被取消资格!
此外,在答辩日期间,评委将在面试阶段进行更仔细的审查和评估,以确保作品的原创性。
HIR投稿
HIR写作注意事项
优秀的参赛作品应力求从平衡的视角全面呈现主题。证据和细致的分析至关重要。投稿应经过充分研究,信息翔实,文风正式严谨。
比赛不接受社论或其他评论文章。文章应有论点,但不应带有任何预设立场。投稿也不应仅仅是事实的堆砌。
比赛要求文章遵循美联社最新版写作风格指南(AP Style),还要求投稿具有文化敏感性、事实准确性,并尊重他人。
所有事实陈述都必须有可靠来源的引用佐证。所有非原创观点都必须注明出处。引用应使用超链接形式。欢迎使用非数字来源,但必须按照美联社风格正确引用。
重新提交政策:参赛者可以选择重新提交文章;但新提交的文章必须与同一比赛年度最初提交的文章探讨不同的主题。
HIR投稿
HIR竞赛评分标准
HIR比赛满分55分,分为内容与选题和风格与规范两大项。
内容与选题部分占30分,包含选题、文章引入、结构与过渡、论据使用、论据分析、论证的整体连贯性六个小项,每小项5分。
风格与规范部分占25分,包含文章语气与基调、拼写标点与语法、是否遵守《哈佛国际评论写作风格指引》、文献引用的规范性、是否易于阅读五个小项,每小项5分。
HIR投稿
HIR竞赛官方赛前培训
提交作品前,参赛者将在哈佛学者和《哈佛国际评论》资深撰稿人的带领下参加5小时线上直播课程
课程一:写作赛要求解读 The Submission Guide
课程二:像搭积木一样写作HIR Article Building Blocks
课程三:资料来源与引用 Sources & Citations
课程四:组织文章框架 Outlining Your Article
课程五:正文写作方法与策略 Drafting Your Article
直播培训课程导师团队由来自哈佛大学的学者们组成
《哈佛国际评论》The Harvard International Review
《哈佛国际评论》是一本季刊,从学者、领导人和政策制定者的角度提供对国际事务的见解。自 1979 年成立以来,我们一直致力于通过出色的写作和编辑选择在学术界和政策界架起桥梁。
是全球顶级社科学术期刊,每期发行量超过10万。主要刊载哈佛学子对于国际事务的多角度看法和理解。供稿人包括学者、教授、领导人、国际问题专家等全世界范围内知名人士。目前已有43位总统和总理、4位联合国秘书长、11位诺贝尔奖获得者发表过评论文章。其编委会由哈佛优秀学者组成,哈佛教授指导。
这一期刊是全球多所名校的必读读物之一。《哈佛国际评论》作为顶级学术期刊,每周都会发表各领域的国际问题研究论文。因此也备受全世界关注,其举办的写作竞赛也吸引了世界各地的目光!